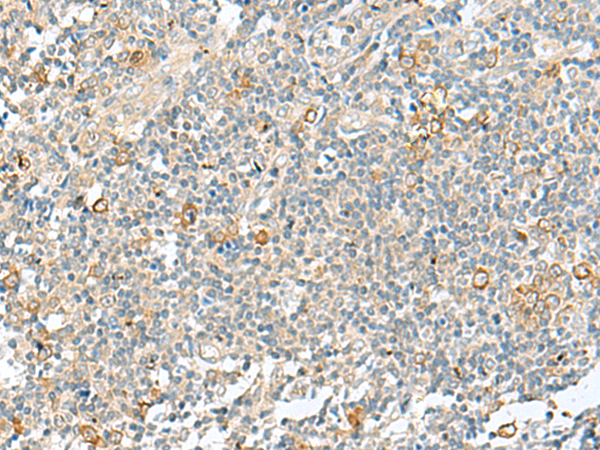

-
分类: 科研抗体货号: P09942别名: MRT15; ERMAN1; ERManI; MANA-ER应用: WB,IHC反应种属: Human, Mouse, Rat
-
分类: 科研抗体货号: P09953别名: C14orf155应用: IHC反应种属: Human
-
分类: 科研抗体货号: P09936别名: GCR2; SGT1; HSGT1应用: WB,IHC反应种属: Human
-
分类: 科研抗体货号: P09941别名: Cocoa; PP13275; calphoglin应用: WB,IHC反应种属: Human, Mouse, Rat
-
分类: 科研抗体货号: P09952别名: DRDL5813; PRO19630应用: WB,IHC反应种属: Human
-
分类: 科研抗体货号: P09935别名: PHTF应用: IHC反应种属: Human, Mouse
-
分类: 科研抗体货号: P09967别名: TCS; MFD1; TCS1; treacle应用: IHC反应种属: Human
-
分类: 科研抗体货号: P09951别名: CLD; DRA应用: WB,IHC反应种属: Human, Mouse, Rat
-
分类: 科研抗体货号: P09934别名: HCR; HRI应用: WB,IHC反应种属: Human, Mouse
-
分类: 科研抗体货号: P09966别名: OTT; OTT1; SPEN应用: IHC反应种属: Human

鄂公网安备42018502007531号
鄂公网安备42018502007531号

